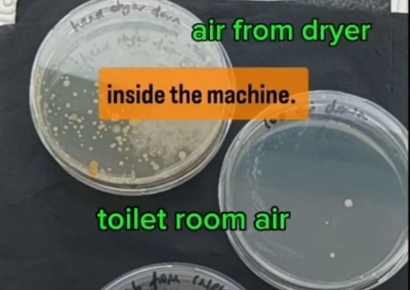
"공중화장실 핸드 드라이어 쓰지 마세요"…英 과학자의 경고

'반값 가전' 들어왔다 소식에 '우르르' 몰려…매출 다섯 배 '껑충'오른 곳
가성비(가격 대비 성능)를 강조한 자체 브랜드(PB) '심플러스(simplus)' 생활용품과 가격 경쟁력을 내세운 '반값 가전' 덕분에 홈플러스의 최근 3개월간 매출이 크게 늘었다. 홈플러스는 1000~1만9000원 균일가로 입소문이 난 심플러스 생활용품의 8~10월 매출이 전년 동기 대비 220% 폭증했다고 17일 밝혔다. 특히 매출 증가에 한몫을 제대로 한 제품은 1000원짜리 수납·정리용 바구니 '스카겐 바스켓'과 '샤워용품·청소솔'로

마른 수건 짜는 정유업계…어린이집도 없앴다
지난 3분기 대규모 적자를 기록한 정유업계가 비용 절감을 위해 직원 복지까지 줄이는 것으로 나타났다. 내년 초 성과급을 기대하기 어렵다는 전망도 나온다. 21일 업계에 따르면 GS칼텍스는 최근 서울 역삼동 본사 인근에 위치한 직장 어린이집을 없앴다. 이 어린이집은 계열사인 GS리테일 직장어린이집으로 간판을 새로 달고 관련 회사 직원의 자녀를 위주로 원생을 받고 있으며, GS칼텍스 일부 직원 자녀만 함께 이용할 수 있도
"공중화장실 핸드 드라이어 쓰지 마세요"…英 과학자의 경고
영국의 한 과학자가 공중화장실에서 손을 씻은 뒤 절대 핸드 드라이어를 사용하지 말고 종이 타월을 쓰라고 경고했다. 공중화장실 핸드 드라이어에는 수많은 박테리아가 있기 때문이다. 최근 영국 매체 데일리메일은 '데본 사이언스(Devon Science)'라는 이름으로 활동하는 과학자의 틱톡 영상을 소개했다. 데본 사이언스는 페트리 접시를 이용해 공중화장실 핸드 드라이어에서 나오는 공기와 일반 공기의 박테리아를 비교했다. 그

CJ, 첫 90년생 CEO 등판…'체험상영관' 콘텐츠 대박의 주역
CJ가 18일 정기 임원인사에서 CGV 자회사 CJ 4DPLEX(4D플렉스) 최고 경영자(CEO)로 1990년대생 방준식 경영 리더를 발탁했다. 1990년대생이 대표를 맡은 것은 CJ그룹 내 최초의 일이다. 유통 업계는 물론 재계로 범위를 넓혀도 비(非)오너가 중 처음이다. CJ는 이날 정기 임원인사에서 CJ 4D플렉스 신임 대표로 방 경영리더를 내정했다. 2018년 CJ 4D플렉스에 경력 입사한 방 신임 대표는 올해 2월 임원으로 이름을 올린 지 불과 9

'1000만 관중' 시대 프로야구…'유통 맞수' 나란히 대박
올해 프로야구가 1000만 관중 시대를 연 가운데 '유통 맞수' 롯데와 신세계가 운영하는 프로야구단들도 일제히 호실적을 거뒀다. 야구장을 찾는 팬들이 늘어난 데다 특화 굿즈 상품들이 인기를 끌면서다. 20일 유통업계에 따르면 프로야구 구단 롯데 자이언츠를 운영하는 주식회사 롯데자이언츠는 올해 3분기 지난해 대비 큰 폭으로 개선된 실적을 냈다. 롯데지주에 따르면 롯데자이언츠를 포함한 롯데의 3분기 기타 부문 매출은

중국의 신형 '드론 캐리어' 얼마나 위협적이길래…미국·대만 '긴장'
중국이 최근 주하이 에어쇼에서 공개한 신형 무인기(드론) 'SS-UAV 제트탱크(Jetank)'의 위협적인 성능에 미국은 물론 전세계가 관심을 보이고 있다. 중국의 신무기는 수천대의 소형 드론을 장거리에 수송할 수 있는 것으로 알려졌다. 중국이 이 드론을 실전 배치할 경우, 군사적 긴장감이 높아진 대만해협 일대에 유사시 막대한 드론 물량공세가 가능하다. 대만 정부는 중국의 물량공세에 대비 중이다. 미국으로부터 드론을 계속

흑백요리사 최현석도 당했다, 진화하는 '노쇼족' 수법
최근 들어 예약 후 나타나지 않는 '노쇼(No-show)' 수법이 지능화되면서 자영업자들의 피해가 심각한 수준에 이르고 있다. 특히 연말을 앞두고 대량 예약 후 노쇼가 급증하는 가운데, 공무원이나 군인을 사칭한 노쇼로 인한 피해 사례가 잇따르고 있다. 2010년까지만 해도 '예약 부도'라는 용어로 불리던 노쇼는 이제 일상적인 단어가 됐다. 하지만 최근에는 단순 노쇼를 넘어 대량 주문과 신분 사칭 등 그 수법이 진화하면서 자영

"이게 뭐야"…휴대폰 확대해보니 벌레가 득실득실 '경악'
현대인들이 온종일 손으로 만지고 심지어 얼굴에 가져다 대기도 하는 스마트폰에 수많은 진드기가 살고 있다는 증거 영상이 공유돼 화제가 되고 있다. 최근 영국 온라인 매체 래드바이블은 '침대 위에 놓은 휴대전화를 당장 치우세요'라는 제목의 영상이 화제가 되고 있다고 보도했다. 이 영상은 휴대전화를 현미경으로 확대해본 모습을 담고 있다. 영상을 보면 스피커 틈새 작은 구멍에 맨눈으로 보이지 않았던 먼지가 가득 쌓여
![[르포]강남 부촌 사로잡았다…먹거리만 채운 롯데슈퍼의 야심작](https://cwcontent.asiae.co.kr/asiaresize/93/2024112115252119723_1732170321.jpg)
강남 부촌 사로잡았다…먹거리만 채운 롯데슈퍼의 야심작
서울 강남구의 대표 부촌 중 하나인 도곡동. 고층 빌딩이 밀집한 지하철 3호선 도곡역과 매봉역을 잇는 도로를 따라 400여세대가 거주하는 주상복합 아파트 입구에 다다르자 초록색 안내판이 입구에서 펄럭였다. 롯데마트·슈퍼가 21일 새단장을 마치고 문을 연 기업형슈퍼마켓(SSM) '그랑그로서리 도곡점'의 개장을 알리는 문구였다. 지하로 연결되는 출입문에 들어선 뒤 미용실과 의류, 주얼리숍 등의 상점을 지나자 1600㎡(약 4

신세계百, 임금피크제 직원 대상 희망퇴직…위로금 지급
신세계백화점이 임금피크제 직원을 대상으로 희망퇴직 신청을 받는다. 물가 인상에 따른 소비침체 영향이 길어지면서 유통업계 전반에 걸쳐 구조조정이 이뤄지고 있는 모습이다. 22일 유통업계에 따르면 신세계백화점은 최근 일부 팀장급 직원 일부를 대상으로 희망퇴직을 제안했다. 이번 희망퇴직은 1969년생(만 55세) 이상 직원 중 팀장급 직책자가 대상으로, 대상자는 100여명 수준으로 알려졌다. 이번 희망퇴직은 공개적으로



![[럭셔리월드]불티나게 팔린 4000만원 BTS 쇼파…장기불황 구매 '뚝'](https://cwcontent.asiae.co.kr/asiaresize/93/2024111510173211589_1731633452.jpg)

!['세차광' 직장인 노하우 대방출…연매출 20억 '대박'[콘텐츠커머스]](https://cwcontent.asiae.co.kr/asiaresize/93/2024111914521416026_1731995534.jpg)






